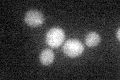
YOR315W
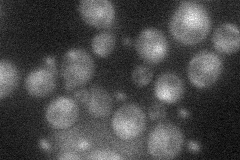
YOR315W
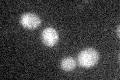
YOR315W

View description
Nuclear protein, putative transcription factor required for growth of superficial pseudohyphae (which do not invade the agar substrate) but not for invasive pseudohyphal growth; may act together with Phd1p; potential Cdc28p substrate
Localization:
Intensity:
Fold change:
Significance:
-
C’ GFP library in SD
cytosol18.15 -
N' NOP1pr-GFP in SD
below threshold27.3179 -
N' TEF2pr-mCherry in SD

below threshold5.70774 -
N' NATIVEpr-GFP in SD

below threshold23.9801 -
N' TEF2pr-VC and Cyto-VN in SD

#N/A0 -
C’ GFP library in SD+DTT

cytosol19.21.05No -
C’ GFP library in SD+H2O2
cytosol19.691.08No -
C’ GFP library in Starvation Media

cytosol180.99No -
C’ GFP library on the background of Pup2-DaMP

cytosol -
C’ GFP library on the background of CCT mutant

cytosol22.05871.21459No
